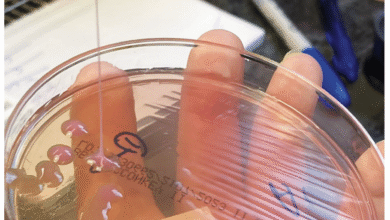
Petri dish with bacterial colonies being streaked with a loop.

▼ Summary
– A 20-year-old man in Taiwan developed a persistent, itchy rash with unusual pigmentation that was initially difficult for doctors to diagnose through standard skin tests.
– The diagnosis was ultimately determined by the patient’s dietary history, specifically his recent switch to a ketogenic (high-fat, very low-carbohydrate) diet.
– A ketogenic diet forces the body into ketosis, a metabolic state where it burns fat for energy, producing molecules called ketone bodies.
– While ketogenic diets have legitimate clinical applications, such as managing drug-resistant epilepsy, this case linked the diet to a specific skin condition.
– The case highlights that dietary changes, like adopting a ketogenic diet, can have unexpected physiological effects, including adverse skin reactions.
A young man in Taiwan sought medical attention for a persistent and puzzling skin condition, presenting with a red, raised, and intensely itchy rash across his shoulders and chest that had lasted a month. The rash was accompanied by patches of darker pigmentation, creating a mottled appearance. A detailed case report published in a leading medical journal documented that a skin biopsy revealed cellular swelling and inflammation around blood vessels, yet standard tests failed to identify a typical cause, leaving clinicians initially stumped. The breakthrough in diagnosis came not from further lab analysis, but from a simple conversation about the patient’s lifestyle.
During his consultation, the man revealed that he had begun following a ketogenic diet approximately two months before his clinic visit, which was about one month prior to the rash’s emergence. This popular dietary approach involves consuming very few carbohydrates while prioritizing high fat intake, fundamentally altering the body’s primary energy source. By drastically reducing carbs, the body is forced to switch from burning glucose to burning fat, a metabolic state known as ketosis.
This shift initiates a complex biochemical process. The body begins breaking down fat tissue, releasing free fatty acids into the bloodstream. These fatty acids travel to the liver, where they are converted into a molecule called acetyl-CoA. When produced in large quantities, acetyl-CoA can overwhelm normal metabolic pathways, leading to the creation of ketone bodies like acetoacetate and beta-hydroxybutyrate. These ketones then circulate in the blood, providing an alternative fuel source for various tissues, especially the brain.
While ketogenic diets have established clinical applications for managing drug-resistant epilepsy and certain rare metabolic disorders, their use has expanded into other areas of interest. Researchers are actively investigating their potential role in addressing obesity, type 2 diabetes, and even exploring connections to cancer metabolism and neurodegenerative conditions such as Parkinson’s and Alzheimer’s diseases. The case of the Taiwanese patient underscores that while the diet may offer benefits for some, it can also lead to unexpected and not yet fully understood side effects, with the so-called “keto rash” remaining a mysterious phenomenon for medical science.
(Source: Ars Technica)